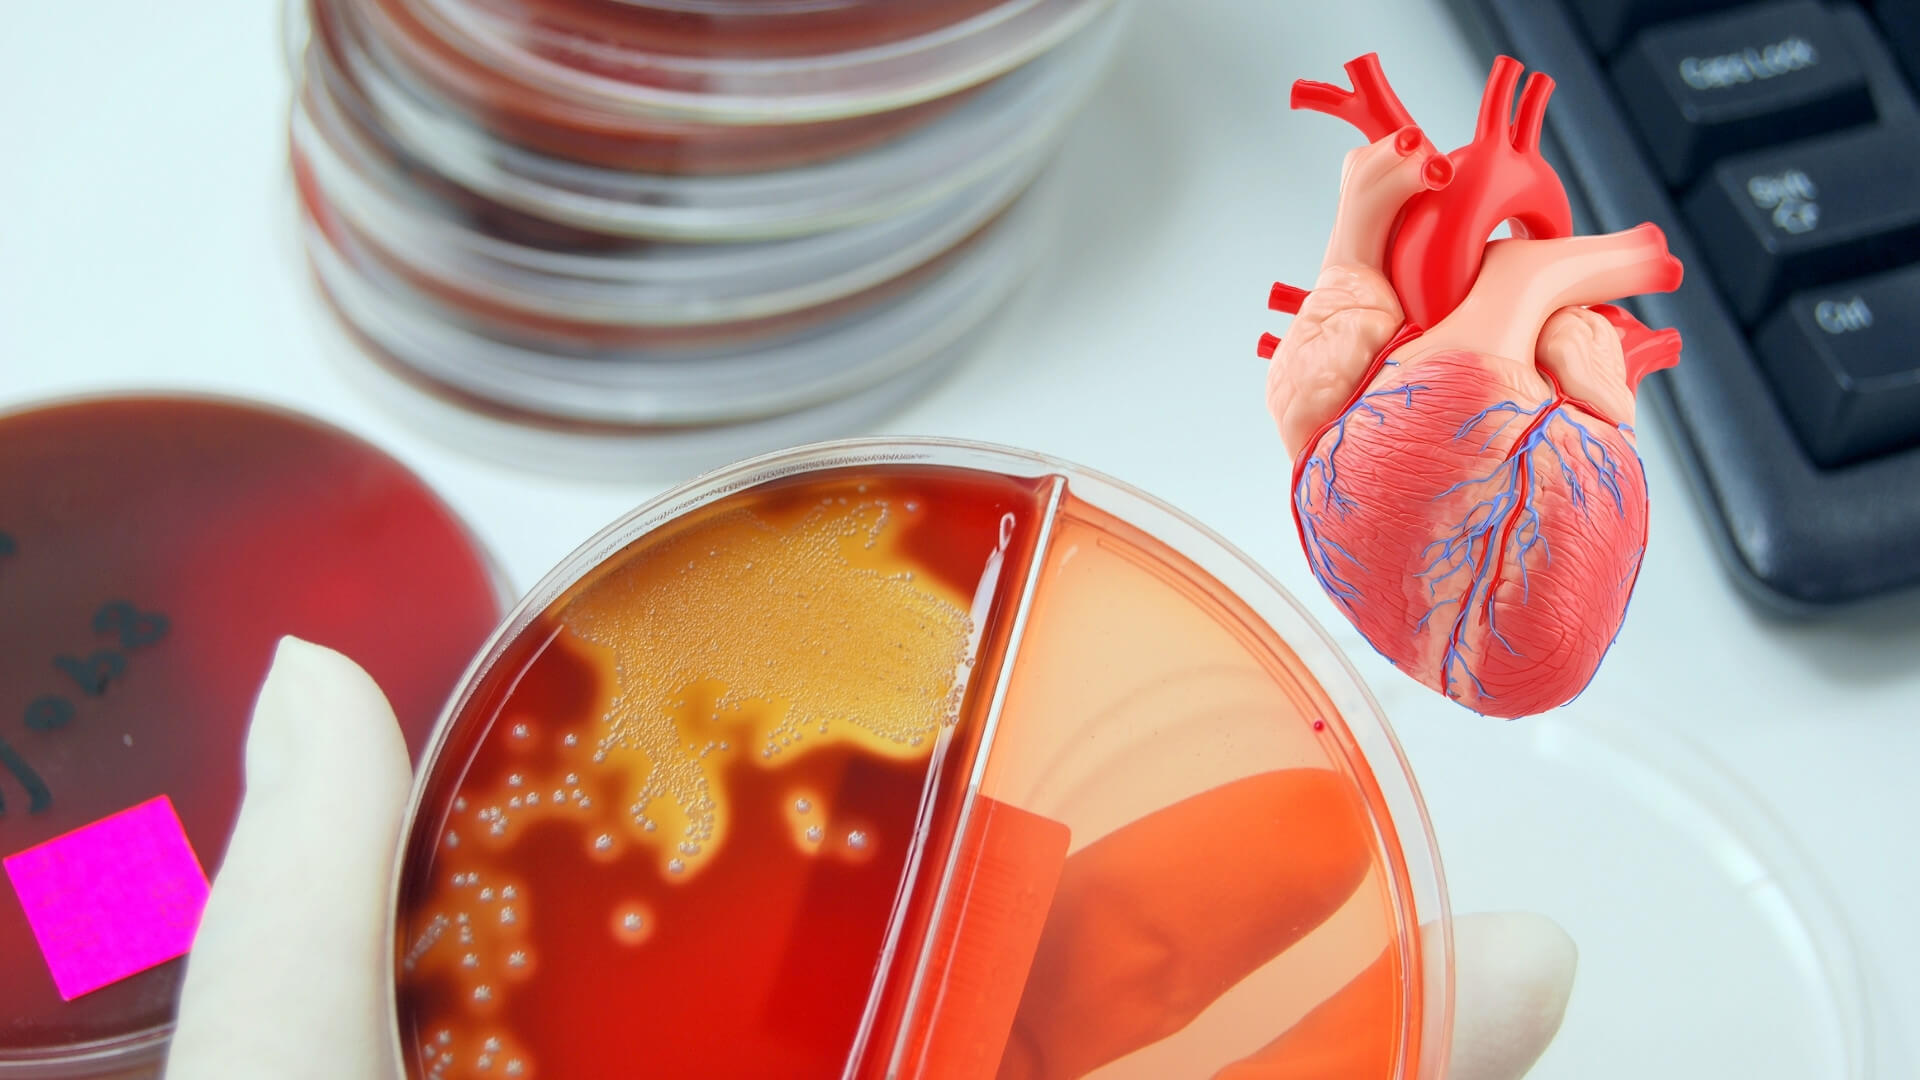
Un hallazgo sorprende a los científicos- bacterias orales se esconden en las arterias y podrían impulsar la ruptura que causa infartos

Imagina una ciudad subterránea, silenciosa, bajo una autopista vital: así viven ciertos microbios orales dentro de las arterias, en colonias pegajosas que el sistema inmunitario no ve y los antibióticos apenas tocan. Cuando esas colonias “despiertan”, liberan bacterias más agresivas capaces de infiltrarse en la capa fibrosa de la placa, encender alarmas inmunitarias y empujarla al colapso. Es la historia que traza un equipo finlandés al rastrear firmas bacterianas y respuestas inmunitarias en arterias de personas fallecidas de forma súbita y de pacientes de cirugía vascular.
La relación entre infección crónica e inflamación arterial no es nueva, pero este trabajo, publicado en Journal of the American Heart Association, la ilumina con un enfoque quirúrgico: mirar directamente dentro de las placas. Los autores estudiaron 121 autopsias de muertes súbitas y 96 muestras clínicas de endarterectomía para buscar ADN bacteriano, biofilm y señales inmunitarias activadas. La suma de dos cohortes distintas aporta un mapa amplio y bien controlado de lo que ocurre en arterias reales, no solo en laboratorio.
Los resultados se enfocan en un grupo de habitantes inesperados: estreptococos del grupo viridans, bacterias habituales en la boca y protagonistas también de endocarditis. El ADN de estos estreptococos apareció en alrededor del 42 % de las placas, tanto en coronarias de autopsia como en muestras quirúrgicas. No fue un hallazgo aislado o anecdótico: la frecuencia y los patrones se repitieron en ambas series.
El detalle cambió el guion: no se trataba solo de bacterias sueltas arrastradas por el torrente sanguíneo, sino de estructuras organizadas. Muchos de estos microorganismos formaban biofilms incrustados en el núcleo graso de la placa, un escondite que los vuelve invisibles a los “radares” de la inmunidad innata. Esa arquitectura, tan propia de las infecciones crónicas, da pistas de por qué tratamientos antibióticos tradicionales fallaron en el pasado.

Biofilms: ciudades invisibles dentro de la placa
Un biofilm es una comunidad bacteriana envuelta en una matriz pegajosa que actúa como escudo. En las arterias analizadas, esa matriz colonizaba el interior de la placa y quedaba fuera del alcance de los macrófagos, las células “basureras” del sistema inmunitario. En imágenes, los investigadores observaron zonas extensas teñidas por anticuerpos frente a viridans sin que los macrófagos reaccionaran.
La calma no dura siempre: en cierto punto, la colonia libera una “nueva generación” de bacterias más virulentas. Esas bacterias dispersadas abandonan el biofilm, atraviesan la tapa fibrosa —la capa que mantiene contenida a la placa— e incendian la respuesta inmunitaria local. El estudio las detectó con fuerte positividad inmunohistoquímica justo en áreas de ruptura.
Ese cambio de fase importa porque conecta la biología microbiana con un evento clínico decisivo. La invasión de la tapa fibrosa y la inflamación resultante son pasos críticos hacia la ruptura de la placa y la formación del trombo que causa el infarto. La fotografía patológica encaja con lo que los cardiólogos ven en las complicaciones agudas.
La firma inmunitaria: TLR2 en el centro del tablero
No bastaba con ver bacterias: había que mostrar que activan alarmas. El equipo evaluó receptores de reconocimiento de patógenos —como TLR2, TLR4 y el correceptor CD14— y encontró su coexpresión en las zonas con bacterias dispersas, junto al encendido del factor NF-κB. Ese es el “botón rojo” que dispara cascadas de citoquinas inflamatorias.
Para afinar la conexión, también probaron en líneas celulares qué rutas activan distintas bacterias orales. En los estreptococos viridans, la vía más activada fue TLR2 (a menudo con TLR1/6), reforzando que esa puerta inmunitaria es una diana clave en la interacción placa-bacteria.
Algunas bacterias gramnegativas activaron TLR4 a bajas concentraciones, pero migraron hacia TLR2 a dosis mayores.
La señal no quedó en vitro: el análisis de expresión génica en placas de pacientes mostró rutas bacteriorreconocedoras sobreactivadas. Los genes del pathway de TLR —incluidos TLR2 y TLR4— aparecieron significativamente sobreexpresados frente a arterias sanas, apuntalando la idea de una inflamación moldeada por estímulos bacterianos. Es una huella molecular coherente con lo observado al microscopio.

Del depósito estable a la lesión vulnerable
No todas las placas son iguales: algunas son estables, otras están al borde de romperse. El estudio halló que la inmunopositividad para viridans aumentaba con la gravedad de la aterosclerosis y se asociaba, en la serie de autopsias, con muerte por cardiopatía coronaria e infarto. No prueba causalidad, pero la correlación es robusta y consistente.
El biofilm permanece latente en el núcleo lipídico, protegido, mientras la placa madura. Ante ciertos desencadenantes —aún por precisar—, se liberan bacterias más “armadas” que alcanzan la tapa fibrosa, activan TLR, atraen células inmunitarias y debilitan el colágeno con proteasas. El resultado puede ser la grieta que expone el contenido de la placa a la sangre y precipita el trombo.
Hay pistas sobre cómo llegan allí. La placa desarrolla neovasos por hipoxia, y esos canales microvasculares podrían servir de puerta de entrada durante episodios de bacteriemia, por ejemplo, tras procedimientos dentales. El mapa histológico mostró neovasos cerca de colonias bacterianas, un detalle que suma verosimilitud al recorrido.
Qué significa para la clínica (y qué no, todavía)
Una conclusión importante es conceptual: las bacterias orales no serían simples “pasajeras” en las placas, sino participantes en procesos inflamatorios que las vuelven peligrosas. Eso reabre líneas de investigación hacia diagnóstico y prevención con foco en biofilms, más allá del control clásico de lípidos y presión.
El propio artículo plantea preguntas pragmáticas: ¿podría un antibiótico de corto plazo, administrado en la fase aguda, modificar el pronóstico del infarto? ¿Podemos desarrollar imágenes que detecten biofilms en arterias? Son hipótesis de trabajo, no recomendaciones clínicas, y exigen ensayos rigurosos tras fracasos previos con antibióticos frente a otros patógenos.
También hay que poner límites a la extrapolación. El estudio es observacional; muestra asociación, arquitectura de biofilm y rutas inmunitarias activas, pero no demuestra causa directa ni cuantifica el beneficio de intervenir sobre bacterias. Además, la detección de ADN bacteriano requiere extremo cuidado para evitar contaminaciones, algo que los autores abordaron con controles y corroboración inmunohistoquímica.

Fortalezas, debilidades y el camino por delante
Entre los puntos fuertes, destaca la combinación de fuentes humanas reales: coronarias de 121 muertes súbitas y 96 muestras quirúrgicas, analizadas con qPCR, inmunohistoquímica, ensayos en líneas celulares y transcriptómica. Esta triangulación de técnicas refuerza que la señal bacteriana no es artefacto de un método aislado.
Las limitaciones también están bien explicitadas: algunas muestras fueron pequeñas o calcificadas, lo que dificultó qPCR; no siempre fue posible correlacionar todos los análisis en la misma pieza; y las autopsias, por definición, sobre-representan ciertos perfiles demográficos.
Aun así, la similitud de perfiles bacterianos entre series de autopsia y quirúrgicas reduce la probabilidad de sesgos críticos. Y los controles negativos en arterias sanas ayudan a anclar la interpretación.
La implicación más amplia es que la aterosclerosis no es solo grasa y colesterol: es también ecología y microbiología. Si los biofilms ayudan a transformar una placa estable en una trampa mortal, detectar y desactivar esa vida oculta podría convertirse en una nueva frontera de la cardiología. Para llegar ahí harán falta biomarcadores fiables, imagen específica y, sobre todo, ensayos que prueben si intervenir en este eje cambia los resultados.
Referencias
- Karhunen, P. J., Pessi, T., Hörkkö, S., Karhunen, V., Goebeler, S., Louhelainen, A. M., ... & Laaksonen, R. (2025). Viridans Streptococcal Biofilm Evades Immune Detection and Contributes to Inflammation and Rupture of Atherosclerotic Plaques. Journal of the American Heart Association. doi: 10.1161/JAHA.125.041521